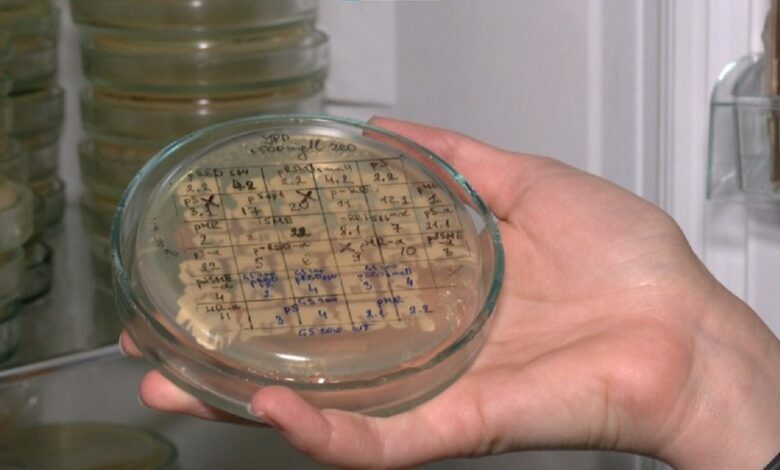
разработка вакцины

Разработку украинской COVID-вакцины больше не ведут из-за нехватки денег и отсутствия интереса у власти
На рынке полно иностранных вакцин
Разработка отечественной вакцины против коронавируса, которую создали львовские ученые, приостановлена из-за отсутствия финансирования и заинтересованности со стороны властей. Об этом заявил руководитель Института биологии клеток Национальной академии наук, академик Андрей Сибирный в комментарии Суспільному.
По словам ученого, вакцина прошла успешное испытание на первом этапе: у подопытных мышей появились антитела к вирусу. Но дальше нужно было проверять, защищает ли вакцина от смерти из-за COVID-19 на трансгенных мышах в Польше, потому что в Украине нет соответствующих лабораторий.
«Не удалось, потому что Национальный фонд исследований Украины морочил нам голову полгода, но так и не разрешил перевести деньги в Польшу, хотя никакого запрета на это нет», – утверждает Сибирный.
«Наше исследование стоило почти 300 тысяч евро. Чтобы сделать вакцину, нужно исследовать на больших животных — сусликах, приматах. Нужны большие объемы препаратов, нужно инвестировать 300-500 миллионов евро. Никто не готов это делать. Я разговаривал с Минздравом, они говорят: «Мы не будем финансировать это. Пусть Фонд этим занимается». Это зависло. Был интерес президента и премьера, когда на рынке вакцин было мало. Теперь вакцин полно. Интереса к ним нет», — добавил он.
На вопрос о перспективах украинской разработки вакцины против коронавируса ученый ответил: «Думаю, дальше оно никак не будет продвигаться». В то же время, по его мнению, разработка собственных препаратов нужна, «потому что развитые государства мало-помалу выпускают хотя бы некоторые вакцины».

А навіщо своя вакцина і що на ній можуть вкрасти чиновники? Інша справа купити, там і відкати і можливості вкрасти.
В Украине асфальт не могут положить нормально, а вы о какой-то вакцине бред несёте. Это просто пздц
А как же президента обещание , бабла отвалить за вакцину ?????? Уже не надо?????